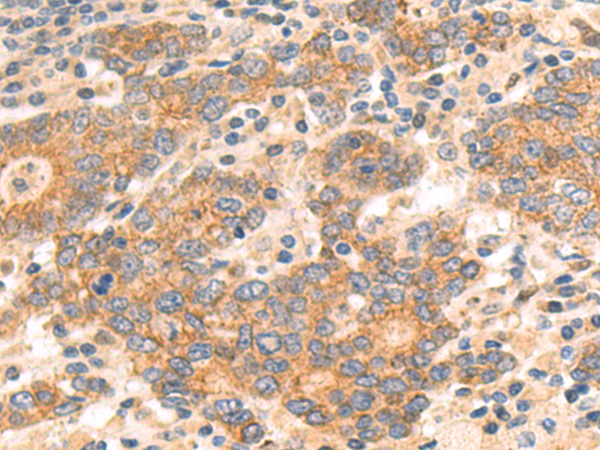

-
分类: 科研抗体货号: P09515别名: CG22; CKAP1; CKAPI应用: WB,IHC反应种属: Human, Mouse
-
分类: 科研抗体货号: P09498别名: CHIL2; YKL39; YKL-39应用: IHC反应种属: Human
-
分类: 科研抗体货号: P09509别名: CIA1; WDR39应用: IHC反应种属: Human, Mouse, Rat
-
分类: 科研抗体货号: P09525别名: RA337M应用: IHC反应种属: Human
-
分类: 科研抗体货号: P09514别名:应用: WB,IHC反应种属: Human, Mouse, Rat
-
分类: 科研抗体货号: P09508别名: CLCR; ELA4应用: IHC反应种属: Human
-
分类: 科研抗体货号: P09513别名: ZCD1; MDS029; C10orf70; mitoNEET应用: WB,IHC反应种属: Human, Mouse, Rat
-
分类: 科研抗体货号: P09523别名:应用: IHC反应种属: Human, Mouse
-
分类: 科研抗体货号: P09507别名: C4ST; C4ST1; C4ST-1; HSA269537应用: WB,IHC反应种属: Human, Mouse, Rat
-
分类: 科研抗体货号: P09521别名: MST130; DFNB102; DFNB103; MSTP130应用: WB,IHC反应种属: Human, Mouse, Rat

鄂公网安备42018502007531号
鄂公网安备42018502007531号

